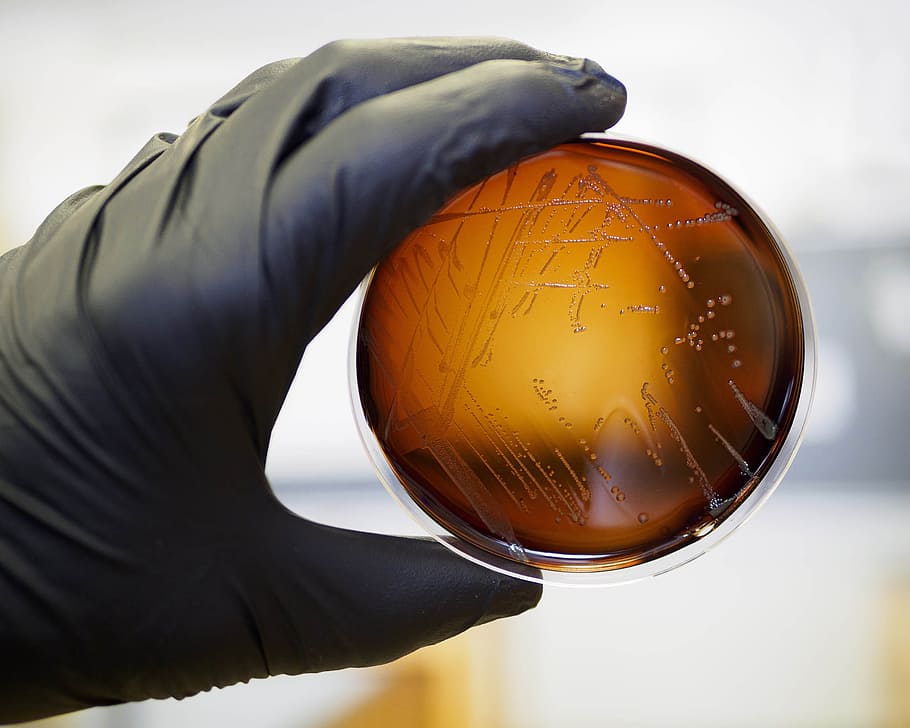

首页 / 产品推荐
-

- IVD新品来袭(Ⅲ类)!美康、达安、诺尔曼、巨东、科智达、见微、泰格科信、利德曼、北方所、昭蓝
-
近日,多家体外诊断企业获得国家药品监督管理局颁发的《医疗器械注册证》。 美康生物科技股份有限公司 CACLP2022展位号:A5-1309 产品名称:新型冠状病毒2019-nCoV核酸检测试剂盒(荧光PCR法) 国械注准:20223401223 批准日期:2022-09-09 无锡科智达科技有限公司 CACLP2022展位号:B2-3313 ..
-

- IVD新品来袭!圣湘、科美、丽珠、卓诚惠生、伯乐、西门子
-
圣湘生物艾滋核酸检测试剂获批上市 CACLP2022展位号:A4-2804 近日,圣湘生物自主研发的人类免疫缺陷病毒1型核酸测定试剂盒(PCR-荧光探针法)通过国家药品监督管理局审核(国械注准20223401175),获批上市。该试剂用于定量检测人血液样本中的人类免疫缺陷病毒1型核酸,监测患者在抗病毒治疗过程中的病毒学应答,此前已获得欧盟CELis..
-
- IVD新品来袭!明德、科华、新产业、亚辉龙、利德曼、博拓
-
点击查看:IVD新品来袭!明德、科华、新产业、亚辉龙、利德曼、博拓
-

- 圣湘生物艾滋核酸检测试剂获批上市
-
近日,圣湘生物自主研发的人类免疫缺陷病毒1型核酸测定试剂盒(PCR-荧光探针法)通过国家药品监督管理局审核(国械注准20223401175),获批上市。该试剂用于定量检测人血液样本中的人类免疫缺陷病毒1型核酸,监测患者在抗病毒治疗过程中的病毒学应答,此前已获得欧盟CEListA类认证。 北京协和医院感染内科主任李太生教授表示: ..
-

- IVD新品来袭!迈克、赛默飞、华大吉比爱、达安、万泰、普迈德
-
迈克生物D600全自动数字PCR分析系统发布 CACLP2022展位号:A3-2801 迈克生物D600全自动数字PCR分析系统,采用自主研发振动微滴(OsciDrop®)核心技术,具有诸多突破性优势。集成了数字PCR检测流程中的微滴生成、PCR扩增和荧光检测三大步骤,全自动化的实验操作极大地缩短了检测时间,可在3小时内完成96样本的自动检测,..
-

- 重磅!助力猴痘诊断试剂开发,诺唯赞高性能猴痘抗体、蛋白及酶原料上市!
-
世界卫生组织7月23日宣布,在多个国家和地区发生的猴痘疫情已构成“国际关注的突发公共卫生事件”(PHEIC),将猴痘病毒(Monkeypoxvirus,MPXV)提升到与新冠同一个级别。截止发稿日,全球猴痘确诊病例已达到3.2万+。据报道,感染MPXV的无症状感染者比例超过13%,且症状经常“非典型”,易被误诊为其他疾病,如性病、新冠,因此MPXV的隐匿传..
-

- 万孚生物又一新品上市
-
炎炎夏日,正是手足口病的高发期。手足口病是由肠道病毒引起的全球性传染病,是全球关注的公共卫生问题。万孚生物(300482)全国独家推出EV71-CA16IgM抗体检测试剂,一份样本检测两个项目,15分钟出结果,有力辅助手足口病诊疗。 手足口病可引起发热和手、足、口、臀等部位的皮疹、溃疡,可伴有上呼吸道感染症状,重症病例可出现神经..
-

- 罗氏冻干分子酶原料——更稳、更快、更灵活
-
新冠肺炎疫情推动了基层医疗分子诊断行业的发展,不论在设施建设,还是专业人员数量都得到充分的发展和储备。并且分子检测的适用性与应用场景在不断扩大,随着技术革新以及使用场景的增多,分子诊断行业规模不断扩大,市场规模增速远高于平均体外检测市场增速。同时我们正身处于更多不确定性的时代,企业需要管理更多的风险。对于IVD行业来说..
扫描下载体外诊断头条APP
扫描关注CAIVD官方微信
扫描关注CAIVD官方视频号
扫描关注CACLP官方微信
扫描关注CACLP官方视频号
全国卫生产业企业管理协会实验医学分会
( 京ICP备15010734号-10 )



